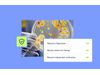

LabHQ LIMS - Laboratory Information Management System
LabHQ supports laboratories across:
- Environmental testing
- Pharmaceutical
- Food and beverage
- Chemicals and petrochemicals
- Manufacturing and quality control
- Contract and third-party testing laboratories
Sample and Data Management
Register, track, and manage samples throughout the full lifecycle with structured data capture and unique sample identification.
Workflow and Workload Management
Organise laboratory processes, allocate tasks, and monitor workload to improve turnaround times and operational visibility.
Traceability and Audit Trails
Maintain clear, time-stamped records of actions and changes to support compliance and audit requirements.
Analysis and Reporting
Capture results and generate reports within a controlled environment, supporting consistent and reliable data output.
Data Access and Security
Role-based permissions and secure access controls help protect sensitive laboratory data.
Stock Management
Track inventory levels, manage batch records, and monitor low-stock alerts within the same system used for testing workflows.
Equipment Management
Maintain equipment records, calibration schedules, and maintenance logs to support operational control.
External User Portal
Share relevant updates and results with external users through controlled access.
- Reduce manual processes and spreadsheet reliance
- Improve data integrity and traceability
- Increase visibility across samples and workloads
- Support compliance in regulated environments
- Scale functionality as laboratory requirements evolve
LabHQ provides onboarding support and ongoing assistance to help laboratories implement the system smoothly and maximise long-term value.
Explore LabHQ by signing up to LabHQ Essentials for free, or contact the team to discuss your laboratory requirements.